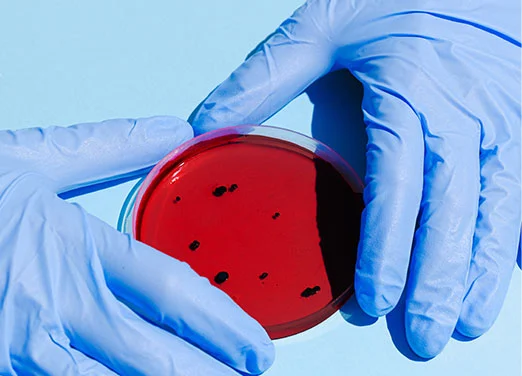

Why do stars twinkle? Is all bacteria bad? How high can birds fly? Join Edufun Academy and CLAIR for an exciting science-filled podcast to find out the answers to these questions and more!

Podcast Episodes

Why do bees buzz?
Edufun Academy is blasting off in her Jetvolt, heading to Hamilton to find the answer to this buzzing question.

What would happen if you got sucked into a black hole?
Edufun Academy goes on an adventure to find out what would happen if a person got sucked into a black hole.

How does microplastic get into the sea?
Edufun Academy, Emma and her friends from Breens Intermediate visit ESR in Christchurch where they meet expert Olga Pantos and find out all about microplastics.

How do planes fly?
Edufun Academy crash lands at Whenuapai Airforce Base with Juanita and some friends from Papakura Intermediate, to find out how planes fly. Handy information for keeping her Jetvolt in the air…

How fast does Santa’s sleigh have to go?
Edufun Academy visits Orakei School to discover how fast Santa’s sleigh would have to go to deliver all his Christmas presents in one day.

Do all animals get goosebumps?
Edufun Academy and some friends find out what goosebumps are and whether all animals get them – especially animals that live in very, very, very cold places.

Where does electricity come from?
Hold onto your hats – Edufun Academy discovers where some of our electricity comes from and it’s blowing a gale.

Edufun Academy’s new adventures
Edufun Academy and her nanobot CLAIR are getting ready for their latest science adventures… Drop into the lab and see what they’re up to – it’s noisy and explosive!
Is all bacteria bad?
Edufun Academy visits a superbugs lab in Auckland to discover whether all bacteria is bad.

Can fish talk?
Edufun Academy goes in search of a conversation with some fish.

What is the slimiest creature in the world?
Edufun Academy takes some students from St Thomas’s School in Auckland to Kelly Tarlton’s to meet a very slippery creature and find out what a hagfish is and why it’s so slimey.

Can we bring dinosaurs back to life?
Edufun Academy visits Te Papa and finds out whether we could bring dinosaurs back to life… And whether we would actually want to.

Can we make plastic that’s better for the environment?
Edufun Academy finds out if we can make plastic that’s not so bad for the environment.

How high can birds fly?
Edufun Academy blasts off in her jetvolt with Jasper and his friends from Mt Cook School as they seek to find out how high birds can fly. Luckily, Gary Miskelly from Te Papa is all aflutter to help them find the answer.

What happens if Antarctica melts?
Join Edufun Academy and some students from Casebrook Intermediate as they brave a blizzard and discover what would happen if Antarctica melted.

What’s the smartest animal?
Join Edufun Academy as she takes a trip to Auckland Zoo to find out what the smartest animal is.

Why do stars twinkle?
Edufun Academy takes Chloe and her friends from Royal Oak Primary to Auckland’s Stardome Observatory to meet expert Josh Kirkley and find out why stars twinkle.
Join our Community
Get up-to-date Edufun Academy news, announcements and free activities for kids, straight to your inbox.

